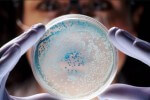

Токсоплазмоз во время беременности: что должна знать о нем каждая будущая мама?
Беременность – особый период, когда нужно внимательнее относиться к своему организму, оберегать его от заболеваний, ведь известно, что они могут отрицательно сказаться на ребенке. Однако совсем спрятаться нельзя от болезней. Не является исключением и токсоплазмоз при беременности. Многие мамочки, услышав от врача такой диагноз, сразу впадают в панику. Но не стоит беспокоиться раньше времени. В первую очередь стоит выяснить, что представляет собой данное заболевание и чем оно опасно.
Токсоплазмоз: понятие и пути заражения
Токсоплазмозом называют паразитарное заболевание, которым страдают люди и животные. Его вызывают токсоплазмы Toxoplasma gondii. Человек и различные виды животных являются лишь промежуточными хозяевами. Окончательный хозяин – домашняя кошка.
В организм людей паразиты могут попасть через пищу. Мясные продукты и яйца, прошедшие плохую термическую обработку, служат источником возможного заражения. В свинине и баранине очень часто содержатся токсоплазмы.
Заболеть токсоплазмозом можно и в том случае, если плохо помыть руки после общения с больными животными и контакта с кошачьими экскрементами.

У многих беременных женщин токсоплазмоз протекает бессимптомно. Узнать о заболевании можно только после сдачи анализов на наличие инфекции. Подтвердят токсоплазмоз при беременности лабораторные показатели.
Симптомы заболевания зависят от его форм. Различают несколько видов:
- острый;
- церебральный;
- врожденный;
- глазной;
- распространенный;
- хронический.
При остром токсоплазмозе наблюдаются следующие признаки: увеличение подмышечных лимфатических узлов, чувство слабости, увеличение температуры тела до 38,0-39,0 градусов, боли в мышцах.
Для церебрального токсоплазмоза характерны головные боли, высокая температура, потеря чувствительности в некоторых областях тела, параличи, кома.
При врожденном токсоплазмозе при беременности симптомы будут следующими: глухота, желтуха, сыпь, большой или маленький размер головки родившегося малыша, задержка психомоторного развития.
Основные симптомы глазного токсоплазмоза: ухудшение зрения, боли в глазах, слепота.
Распространенный токсоплазмоз протекает без поражения головного мозга и глаз. Его проявления различны, так как обусловлены воспалением сердечной мышцы, легких и т.д. Органы, подвергшиеся воспалению, могут перестать работать.
Хронический токсоплазмоз при беременности проявляется раздражительностью, снижением памяти, невротическими реакциями, тошнотой, вздутием живота, запором. Самые важные симптомы – специфический миозит и миокардит.
Опасен ли токсоплазмоз для беременных?
Токсоплазмоз во время беременности абсолютно неопасен для женщин, которые задолго до зачатия перенесли данное заболевание. На него вырабатывается иммунитет.
Если же женщина не болела ранее токсоплазмозом, то для нее и ребенка он будет очень опасным. Риск заражения плода с каждым месяцем беременности становится выше. Например, в первом триместре риск заражения малыша составляет 15%, во втором – 30%, в третьем – более 60%.
Тяжесть заболевания со сроком не увеличивается, а наоборот, снижается. Если женщина заразилась токсоплазмозом во время беременности в первом триместре, то вероятность того, что плод погибнет, очень высока. Практически всегда происходит выкидыш. Даже если ребенок и родится, то у него могут иметься серьезные поражения головного мозга, селезенки, печени, глаз.
Диагностика токсоплазмоза
Для того чтобы определить, заражена беременная токсоплазмозом или нет, проводят серологический анализ крови. Перед врачом стоит нелегкая задача – не только обнаружить инфекцию в организме, но и определить, является она старой или свежей. Чтобы это узнать, медицинский работник определяет наличие иммуноглобулинов класса G и M (IgM, IgG).
Норма токсоплазмоза при беременности – наличие стабильного IgG показателя и отсутствие IgM-антител.Если в крови есть только иммуноглобулины класса M, то это означает, что заражение произошло совсем недавно. Такая ситуация для женщины в положении крайне неблагоприятна. Если срок небольшой, то возможен выкидыш. Если этого не происходит, то врачи рекомендуют прерывание беременности, так как у малыша будут серьезные проблемы со здоровьем. На более поздних сроках проводится лечение.

Если при анализе на токсоплазмоз при беременности обнаруживаются иммуноглобулины обоих классов, то это указывает на то, что женщина заразилась давно, и инфекция в организме находится около года. В таком случае рекомендуется повторное исследование через несколько недель.
При обследовании иммуноглобулины могут быть вообще не обнаружены. Беременной женщине нужно будет соблюдать все меры предосторожности в течение всего срока, ведь ранее она не болела токсоплазмозом, и иммунитет к данному заболеванию у нее отсутствует.
Часто при анализе врач констатирует наличие иммуноглобулинов класса G и отсутствие иммуноглобулинов класса M. Это свидетельствует о том, что ранее инфекция была в организме, но в настоящее время к ней выработан иммунитет. Антитела к токсоплазмозу при беременности сохраняются в организме на долгие годы (около 10 лет). Таким образом, встреча с инфекцией не грозит абсолютно ничем.
Лечение токсоплазмоза при беременности
Лечение токсоплазмоза у беременных женщин обязательно. Врач, диагностировав данное заболевание, определяет схему и длительность предстоящего лечения.
Стоит отметить, что лечить токсоплазмоз можно с 12-16 недели. Однако врачи больным женщинам рекомендуют прервать беременность, если ее срок составляет менее 24 недель. Это связано с тем, что для лечения заболевания используются антибиотики. На раннем сроке вредного воздействия препаратов на плод нельзя избежать.
Чаще всего врачи назначают своим пациенткам препарат, обладающий высокой эффективностью. Ровамицин значительно снижает риск передачи инфекции ребенку. Кроме этого, данный антибиотик хорошо переносится большинством женщин.
Все препараты при токсоплазмозе и беременности принимаются только по назначению врача. Заниматься самолечением не нужно.
Профилактика заражения токсоплазмозом
Беременные женщины, никогда не болевшие токсоплазмозом, могут избежать заражения этой страшной инфекцией. Для этого нужно всего лишь тщательно соблюдать правила гигиены.
Профилактические мероприятия:
- исключить из своего рациона термически необработанное мясо, рыбу. Не рекомендуется во время беременности кушать суши, ведь именно в продуктах, из которых готовится данное блюдо, могут содержаться паразиты, вызывающие токсоплазмоз;
- не пробовать сырой фарш. Многие хозяюшки, готовя еду, пробуют фарш на вкусовые качества. Тем самым они подвергают себя риску заразиться токсоплазмозом при беременности;
- тщательно мыть руки после контакта с домашней кошкой, уборки ее туалета, приготовления мясных блюд, работы на огороде или в саду;
- тщательно мыть овощи, зелень, фрукты, ягоды;
- обследовать на наличие паразитов токсоплазмоза домашнюю кошку и при необходимости вылечить ее. Лучше всего на время избавиться от животного, отдав его родителям или друзьям;
- не ходить в гости родственникам, друзьям и знакомым, у которых дома живет кошка.
Соблюдение всех этих профилактических мероприятий позволит беременной женщине без иммунитета защитить себя и своего еще не родившегося малыша от инфекции.
Таким образом, стоит отметить, что токсоплазмоз не опасен для беременных женщин, которые ранее переболели данным заболеванием и у которых есть иммунитет. При повторном заражении они даже не нуждаются в лечении. Токсоплазмоз не причинит вреда ни будущей маме, ни ее плоду.
Женщина, которая ранее никогда не сталкивалась с данным заболеванием, при соблюдении профилактических мер может не беспокоиться о возникновении токсоплазмоза. Если же все-таки заражение произошло, то последствия токсоплазмоза при беременности могут быть плачевными, так как есть вероятность потерять ребенка.
Советуем почитать: Есть ли секс после родов? Какие проблемы мешают супругам вернуться к полноценной интимной жизни после беременности и как с ними справиться

Первый раз прочла о токсоплазмозе из поста своего врача, у которой веду беременность и решила ещё статьи почитать на эту тему. Спасибо за информацию.
Если кто-то захочет больше узнать по этой тему, то можно врачу вопросы задать прям на фейсбуке
Это врач ТН-Клиники, Титова Елена Ивановна